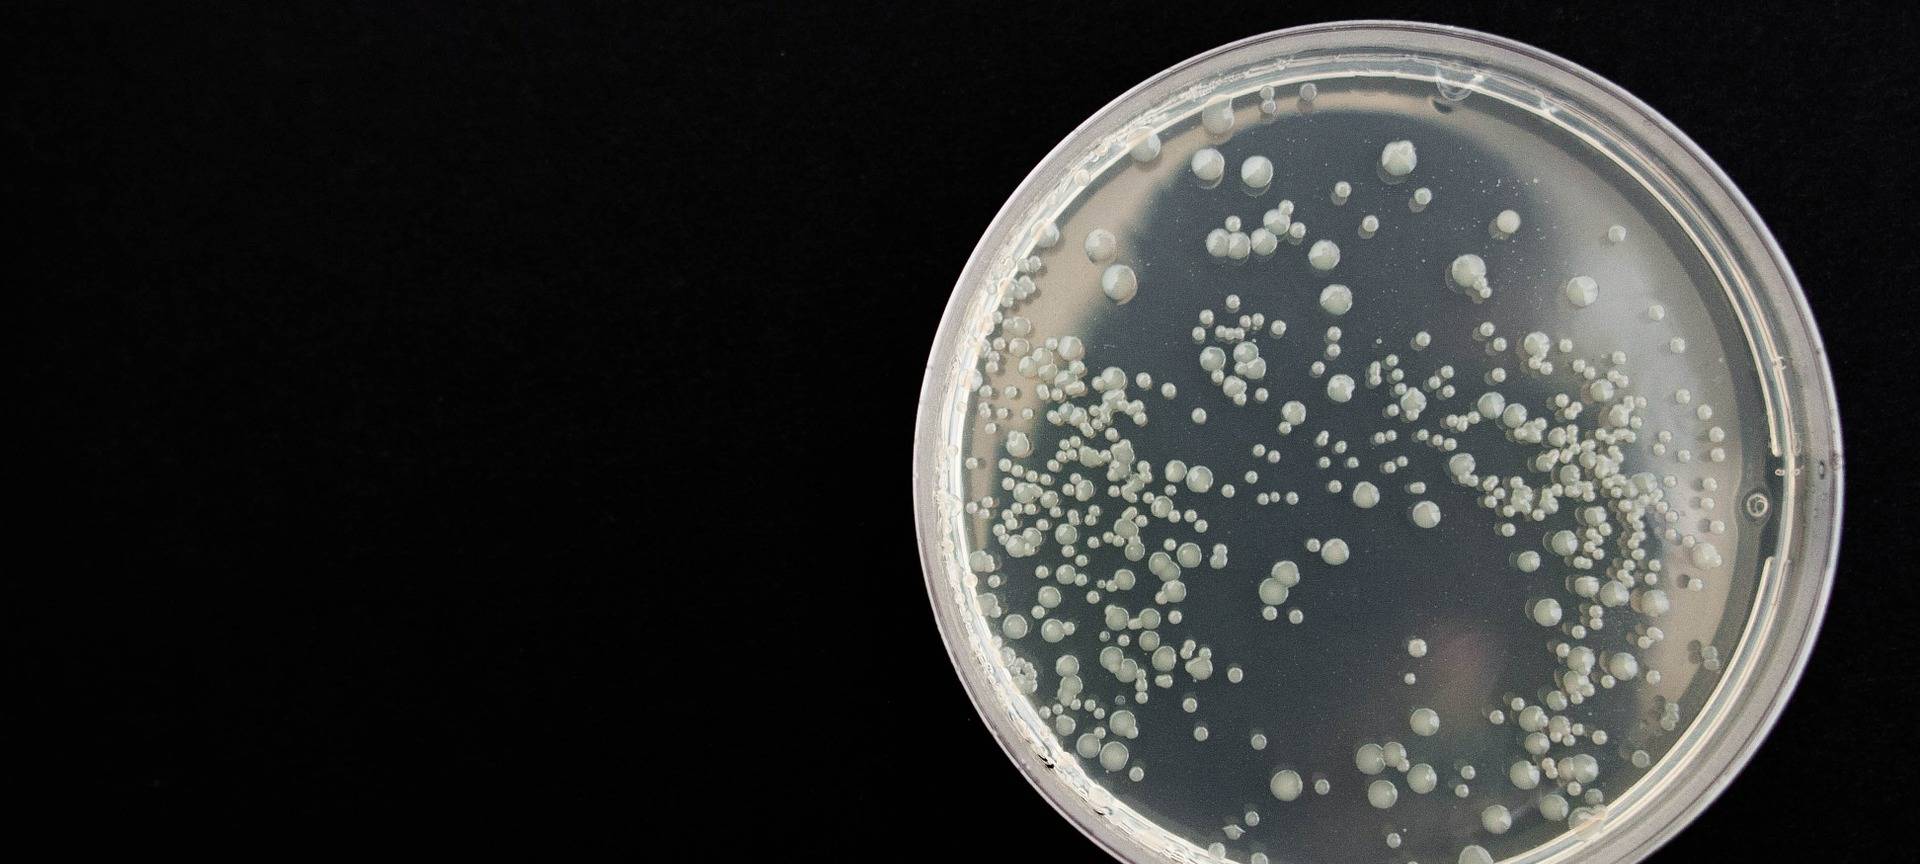
Anstieg der Krätze-Fälle in Dortmund

© Pixabay
© Pixabay
Anstieg der Krätze-Fälle in Dortmund
Auch in Dortmund ist die Anzahl der Krätze-Fälle in den vergangenen Jahren gestiegen. Genaue Zahlen habe das Gesundheitsamt nicht. Die Meldepflicht der Kindertagesstätten, Grundschulen und Pflegeheime werde nicht kontrolliert, sagte der Leiter des Gesundheitsamtes Dr. Frank Renken. Teilweise würde auch ein bloßer Hautausschlag als Krätze eingestuft.
Veröffentlicht: Donnerstag, 11.04.2019 07:17
Anzeige
Die ansteckende Hautkrankheit wird durch Parasiten, so genannte Krätzmilben, ausgelöst. Direkt von Mensch zu Mensch sei die Krätze nur bei einem längeren engen Hautkontakt ansteckend, so Renken.
Anzeige
Anzeige